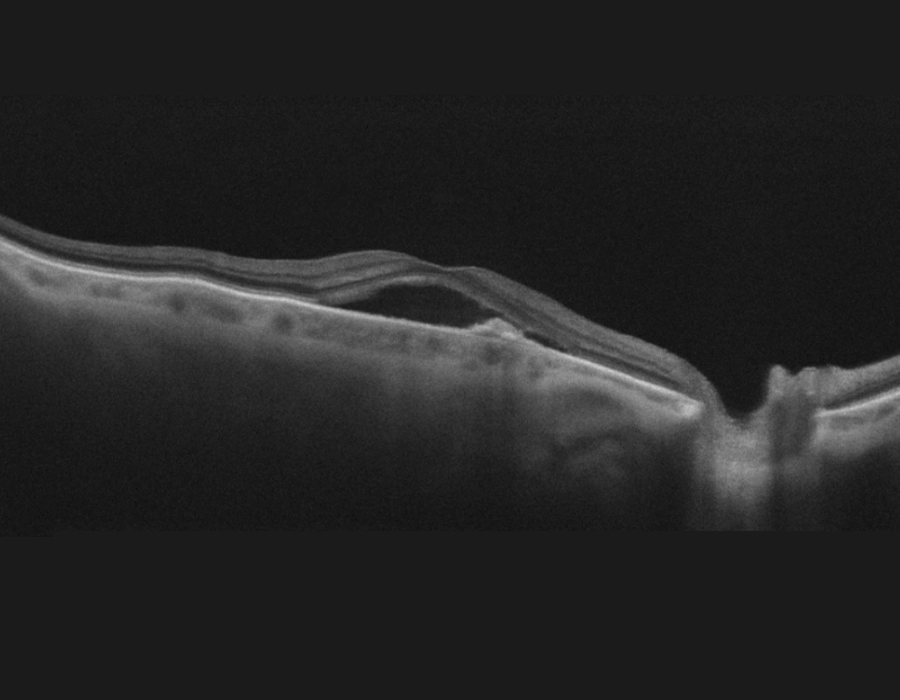
OCT image of retina of right eye with AMD before treatment
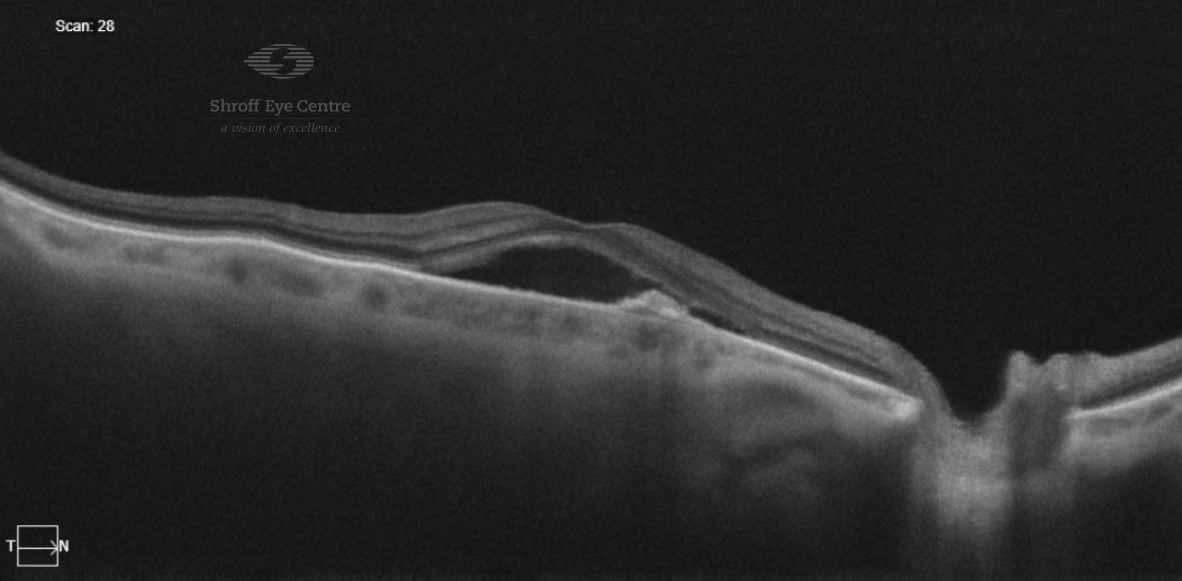

As a family from Dehradun, we had the privilege of experiencing exceptional care at Shroff Eye Centre ,Kailash colony ,Delhi for my 69-year-old mother's advanced Vitreo-Retinal(macular hole) surgery.
I'm overwhelmed with gratitude for the outstanding treatment she received.
Dr. Darius's expertise shines through in every aspect of his work, and his impressive qualifications, including being a Fellow of the Royal College of Surgeons, highlight his commitment to upholding the highest standards in surgery.
From the moment we stepped into the centre, the staff's professionalism and kindness impressed us. The liftman, nurses, reception counselors, and anesthetists were all courteous and efficient.
Dr. Darius's skill, experience, and compassion gave us immense confidence throughout the surgery process. His team worked seamlessly together to ensure my mother's comfort and safety.
The centre's integrated computer system is also noteworthy, ensuring that all patient information is readily available and no detail is missed. This level of organisation and optimal use of technology clearly contributes to the high standard of care provided.
Although we had to travel far for the surgery, it was worth every bit.
I wholeheartedly recommend Shroff Eye Centre and Dr. Darius to anyone seeking world-class eye treatment.
Their commitment to delivering exceptional patient care is truly commendable."
I give : 5/5 stars to Shroff eye centre
Your Eyes, Our Passion
Age-Related Macular Degeneration (AMD): Symptoms, Diagnosis & Treatment in Delhi NCR
Overview
Age-related Macular degeneration is an eye condition that affects the macula, the central part of the retina which is responsible for sharp, detailed vision. Aging is one of the main risk factors. It causes distortion in vision and affects central vision. Age- related Macular degeneration can be treated but can not be cured yet.
Content
Types of Age-related Macular Degeneration (AMD)
There are two types of AMD: Dry & Wet
Dry AMD (also called non-neovascular or Atrophic AMD)
Dry AMD is the most common type of AMD. It accounts for 80-90 % of the cases of AMD. This is when the macula starts degenerating with age. This happens due to deposition of yellow lipo-proteinaceous material, called drusen, under the retina.
Central vision loss occurs gradually in Dry AMD. Vision loss may not be noticeable in earlier stages of Dry AMD and can deteriorate gradually as the disease progresses. Vision loss may become noticeable in advanced stages of Dry AMD called Geographic atrophy. In some cases the dry form can change into wet AMD.
Wet AMD (neovascular AMD)
Wet AMD is a type of AMD and more serious form of Age-related macular degeneration. In this form, abnormal blood vessels grow under the retina and macula. These vessels leak blood and fluid under the retina.
Vision distortion and central vision loss is faster in wet AMD. Wet AMD has more rapid onset and progression.
Symptoms of Age-related macular degeneration (AMD)
AMD often develops very slowly- which is why many people do not notice any changes in vision in its early stages. Symptoms include
- Distorted vision- Straight lines appear wavy, bent, or crooked (metamorphopsia)
- Difficulty reading fine print or seeing details
- Dark or blank areas in the center of vision (Central blind spots or scotomas)
- Problems with depth perception
- Not able to see as before in less light
- Reduced contrast sensitivity: Difficulty distinguishing between similar shades
- Difficulty adapting to changes in lighting
As AMD advances, it may cause
- Significant central vision loss
- Complete loss of reading ability
- Inability to recognize faces
- Difficulty with daily activities such as reading or seeing your mobile phone which requires detailed vision
Risk Factors of AMD
The following increase the risk for Age related Macular Degeneration (AMD):
- Age: Aging is the most significant risk factor. Risk increases dramatically after age 60, with the highest prevalence in those over 85.
- Family history: Those with family history of AMD have a higher risk factor.
- Gender: Women may have slightly higher risk, possibly due to longer life expectancy
- Ethnicity: Higher prevalence in Caucasian populations
- Smoking: smokers have a higher risk of AMD
- Cardiovascular Disease: High blood pressure, high cholesterol, and heart disease are associated with increased AMD risk
- Obesity: Being overweight increases the risk of developing AMD
- Lifestyle factors: Sedentary lifestyle, poor sleep habits and high stress levels may also contribute to AMD
- Diabetes mellitus
Diagnosis of AMD
Early detection is crucial for managing AMD effectively. At Shroff Eye Centre's retina department we employ state-of-the-art diagnostic technologies to diagnose AMD.
Our eye specialists first do a Comprehensive Eye Examination which includes
- Visual acuity testing: Measures sharpness of central vision and how well you’re able to see
- Amsler grid test: Using a chart and this helps detect distortions in central vision
- Dilated fundus examination: Eye drops are used to dilate the pupil (central black circle in the eye) which allows direct visualization of the retina and macula
After the comprehensive eye exam, our doctors will request some imaging to see the retina in detail.
Optical Coherence Tomography (OCT)
- OCT provides cross-sectional images of retinal layers and detects any fluid accumulation, deposition of protein (drusen), and any structural changes in the macula and retina
- OCT is the gold standard for AMD diagnosis and monitoring the treatment
- OCT is essential for treatment planning and monitoring of AMD
Optical Coherence Tomography Angiography (OCTA)
- OCT-A is a newer advancement which allows non-invasive visualization of retinal blood vessels
- It is quicker than FFA and allows detailed imaging without injection of a contrast dye
- It is excellent modality for monitoring treatment response
Fundus Fluorescein Angiography (FFA)
- FFA involves injection of an intravenous dye to visualize blood vessels
- The dye is injected into a vessel of the hand or arm and it travels to the blood vessels in the eye. A special camera is used to look at your retina and take pictures of the blood vessels as they appear brightly lit up through the camera.
- It identifies abnormal vessel growth and leakage of fluid and blood into the retina or vitreous.
- It is important for diagnosis of wet AMD and planning treatment.
Fundus Autofluorescence
- This may be done to map metabolic activity in retinal cells
- It helps detect early changes in AMD and geographic atrophy and helps monitor disease progression
AMD treatment in Delhi NCR
Treatment for AMD depends on the stage and type. Right now, there is no permanent cure for AMD and treatment is aimed at preserving vision and preventing further visual loss. Quitting smoking, weight management and regular eye checkups are important in AMD.
Dry AMD Treatment
Early Dry AMD requires no intervention. Nutritional supplements in a specific combination work to slow down vision loss and progress in Dry AMD. For Late stage Dry AMD, also called Geographic atrophy, there was no treatment available till recently. Today, two new therapies are available for Geographic atrophy. Read more
Wet AMD Treatment
Wet AMD is an advanced form of AMD and usually affects vision. While there is no cure for wet AMD yet, there are 2 treatment options that may slow down or stop vision loss from wet AMD
- Anti-VEGF injections: medication given directly as injections (intra-vitreal) into the eye which stop the formation of the abnormal blood vessels in the retina.
- Photodynamic therapy: a combination of injections and laser treatment to stop new vessel proliferation in retina and macula – reserved for a few sub-set of the cases.
Your retina specialist will choose a treatment strategy after doing a thorough eye exam. Read more about Treatment of Age-related Macular Degeneration here.
Prevention of AMD
While AMD cannot be completely prevented, some of these modifications of risk factors have shown a reduction in risk of getting AMD or slowing down progression of AMD
Dietary Recommendations for Age-related macular degeneration (AMD)
- Eat a balanced diet rich in anti-oxidants from natural sources such as whole grains, fish, nuts and a variety of fruits & vegetables.
- Limit ultraprocessed foods or foods high in saturated fat or trans-fat, refined sugars and sodium unless recommended by your doctor.
Lifestyle Modifications
- Smoking Cessation: It is Single most important preventive measure in AMD. Studies have shown risk reduction begins almost immediately after quitting
- Regular Exercise: WHO recommends 150 mins of moderate intensity Aerobic activity every week spread through the week and strength training at least 2 days per week for optimal health. Exercise improves circulation and overall health along with eye health.
- Weight management: Maintaining a healthy weight reduces AMD risk and progression
- Cardiovascular Health: Managing blood pressure, lipids, and diabetes reduces risk of AMD and slows down its progression.
- UV Protection: Use High quality sunglasses with UV protection and Wide-brimmed hats for outdoor activities especially in areas with high UV intensity
Regular Eye Examinations
- Annual comprehensive eye exams where the eyes are dilated are important for all age groups, especially if you have any eye problems.
- Early detection, monitoring of the retina and early treatment are important to preserve vision in AMD
FAQs on AMD
Can AMD be cured?
As of 2025, AMD cannot be cured but it can be treated. Treatment exists to slow down progression of AMD, preserve vision. Timely management in wet AMD can restore vision. Early detection and treatment are important for better outcomes. Lots of research is ongoing to try to find a permanent cure for AMD but no cure is yet available.
Can I go completely blind from AMD?
Complete blindness i.e zero vision due to AMD alone is rare. AMD typically affects only the macula i.e. the central part of the retina. This means it mostly affects the central vision leaving peripheral vision intact. Central vision is responsible for the sharpness and details in our vision. Most people retain some functional vision and can continue many daily activities with appropriate support, occupational therapy and low vision aids.
Can both eyes be affected by AMD?
Yes, AMD often affects both eyes, though usually not simultaneously or to the same degree. If you have AMD in one eye, the risk of developing AMD in the other eye increases.
How quickly can AMD progress?
It is difficult to predict progression in AMD.
Usually, Dry AMD typically progresses slowly over years, while wet AMD can cause rapid loss of vision. The progression from dry AMD to wet AMD may also happen very quickly. This is why regular eye checkups are essential to keep a watch on symptoms.
How often should I have my eyes examined if I have AMD risk factors?
This question is best answered by your retina specialist.
Usually, those with risk of AMD must get an annual dilated eye check up at the very least.
Those with early or intermediate AMD may be asked to follow up more often (3- 6 monthly) depending upon their risk factors, symptoms and eye examination.
Those with Advanced AMD must get their eyes examined as recommended by their retina specialist. This may be monthly if Anti-VEGF treatment is ongoing.
Can younger people develop AMD?
This is quite rare as age remains the main risk factor for age related macular degeneration. Rarely it can occur in people under 50 especially in those with strong genetic risk factors or underlying health conditions. Anyone at risk of retina problems must get at least annual dilated eye check-ups. Read more on risk factors of AMD here.
Are AMD treatments painful?
No, most people do not find AMD treatments physically painful. People may get annoyed at how often they have to follow up during active treatment but unfortunately this is necessary for the safety of your eyes and for preservation of vision.
During Anti-VEGF injections patients experience mild discomfort during injection, but overt pain is not usual as topical anesthesia is used.
Supplements for AMD are taken orally, i.e. by mouth, and thus are not painful. Read more about AMD treatment here
Does diet really make a difference in AMD?
Yes, there is strong evidence to support the role of diet and nutrition in AMD. These studies have established that a well balanced diet rich in anti-oxidants (including minerals & vitamins) and omega-3 fatty acids play an important role in preventing the development of AMD or slowing down its progression. The AREDS1/ AREDS2 studies showed that a specific dose and combination of these anti-oxidants, minerals and vitamins were beneficial in AMD. Read more here
If my father has AMD, can I get it too?
Yes, many genes are involved in AMD and it does run in families. Those with a parent or sibling with AMD have a 3-6 times higher risk of AMD. However, just having a genetic predisposition alone doesn't mean you'll definitely develop AMD. Your risk of AMD can be modified by changing other risk factors like lifestyle, diet and smoking. Please also see a retina specialist.
Can I drive with AMD?
Driving ability depends on the severity of AMD and your visual status.
Early stages: In early AMD, vision is usually not affected or may be corrected with some visual aids
Advanced stages: In later stages of dry AMD or wet AMD, central vision is usually affected. It is safer for you to not drive at this stage.
Can blue light from phones worsen my AMD?
Screens/ blue light from devices alone do not cause AMD or worsen AMD. Compared to the risk from aging, smoking, cardiovascular disease, and being overweight, exposure to typical levels of blue light from consumer electronics is negligible in terms of increased risk of macular degeneration or blindness. The blue light in sunlight is far higher than emitted from devices. However, disruption of sleep caused by excessive use of these devices may have a negative impact on your overall health- which may worsen AMD.
Are there any new treatments in AMD?
- There is a lot of research ongoing in AMD. In the last few years many new options have emerged, though not all widely available in India yet.
- Newer Anti-VEGFs like Vabysmo etc introduced in India are available at Shroff Eye Centre
- New medicines approved for late stage Dry AMD-Pegcetacoplan (SYFOVRE) and Avacincaptad pegol (Izervay). Currently approved in the US, and not yet widely available in India.
- New light therapy devices recently approved by FDA
- Gene therapy trials & stem cell trials ongoing. Read more about the latest treatment in AMD here.
Retina Patient Testimonials
See the Difference
Why Shroff Eye Centre?
1
Excellence
in Eyecare since 1914
2
Award winning
Eye specialists
3
Empathetic
Personalised patient care
4
Advanced care
1 lac happy eyes / year
5
Ethical
Patient-first approach
Patient Reviews
Great experience from the reception till departure. Dr. Cyrus is a great clinician and retina expert, thorough and reassuring. Indeed an authority in the subject. Thanks.
I had an excellent experience with Dr. Gagan Bhatia retina specialist. From the moment I walked in, the staff was warm and professional. Dr. Gagan Bhatia took the time to explain my condition in detail, answered all my questions patiently, and made sure I felt at ease throughout the process. The treatment was smooth, and I noticed a clear improvement in my vision. I highly recommend anyone with retina issues to visit them — truly an expert in the field.
I had a wonderful experience with Dr. Gagan Bhatia. He is not only highly skilled but also extremely patient and understanding. He took the time to explain my condition in detail, answered all my questions, and made me feel completely at ease throughout the treatment process. His expertise as a retina specialist is evident, and I felt confident and well cared for at every step. The staff was also very supportive, and the clinic was well-organized. I truly appreciate his professionalism and compassion and would highly recommend Dr. Gagan Bhatia to anyone seeking expert eye care.
I had a retina surgery and developed a glaucoma and then cataract , as with the young age it’s too dark time to go thru , but then some how I got a reference of DR. JASLEEN from Dr.Shroff centre kaushambi and got operated cataract on one of my eye . I should address here , that she is such a great expertise ,to me as a patient she was so polite to attend calls whenever I call her due to sudden phobia of eye treatments . Dr .jasleeen is most amazing and wonderful doctor . Still my routine check up is continuing with her . She is such a sweet as a person and as professional . And yes outcome of surgery is amazing and superb .
AMD Treatment Near You
Kailash Colony
A-9, Lala Lajpat Rai Rd, Block A, Kailash Colony, Greater Kailash, New Delhi, Delhi 110048
South Delhi areas- Greater kailash, Lajpat nagar, Cr park, Defence colony, Niti bagh, Saket, Noida
GET DIRECTIONS
Connaught Place
Building (1st floor, 105, Surya Kiran, 19, KG Marg, New Delhi, Delhi 110001
Central Delhi- serving Karol bagh, Rajender Nagar, Civil lines
GET DIRECTIONS
Gurgaon
110 Bestech Chambers Radisson Suites, Block B, Sector 27, Gurugram, Haryana 122009
Haryana- Golf course road, Cyber city, Rewari, Sohna, Faridabad
GET DIRECTIONS
Ghaziabad
509, KM Trade Tower, adjacent to Radisson Blu, Sector 14, Kaushambi, Ghaziabad, Uttar Pradesh 201010
GET DIRECTIONS
Uttar Pradesh- Greater Noida, Ghaziabad, Merut, Bulandshahr, Hapur
Medical content reviewed by Shroff Eye Centre.
Updated : October 2025
Disclaimer
This is not medical advice. Your ophthalmologist will help you decide which procedure and lens is best suited for your eyes. Every patient and eye is different and thus the experience for every patient is variable.
All product and company names are trademarks or registered trademarks of their respective holders. Use of them does not imply any affiliation or endorsement by them.

By being on the website, your personal data is being processed for communication with you and providing services. We use cookies to collect and analyse information on site performance, usage, enhancement of customer usability and improvising the website. We have put in place terms of use,
By clicking on accept you agree to all the policies mentioned above. You can read more about them by clicking on read more and accept them individually.






 Call us
Call us Email us
Email us







